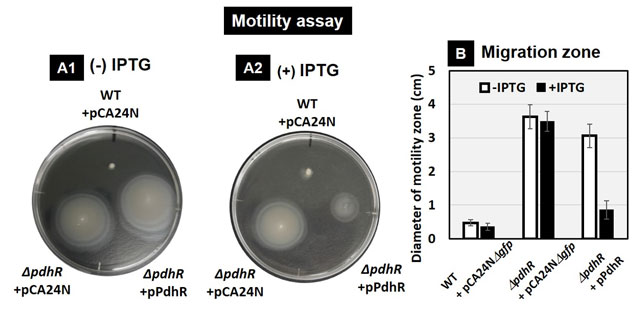
図3. PdhRが運動性に与える影響。軟寒天培地上での大腸菌の運動性試験結果(A)とその比較(B)。

東工大ニュース
東工大ニュース
公開日:2020.10.07
ピルビン酸は全生物共通で、代謝経路の中心に位置しており、様々な細胞構成成分の基質となる重要な炭素化合物です。細胞内ではその濃度の恒常性を維持するために、厳密な制御が行われています。大腸菌では細胞内のピルビン酸濃度を感知する転写因子PdhRによる遺伝子発現制御が知られています。これまでにPdhRはピルビン酸デヒドロゲナーゼや電子伝達系を制御することが報告されていましたが、その役割の全体像はよく分かっていませんでした。明治大学農学部 島田友裕准教授、安西拓実(博士前期課程2年)は、法政大学マイクロ・ナノテクノロジー研究センター 石浜明客員教授、東京工業大学科学技術創成研究院化学生命科学研究所 今村壮輔准教授と協力して、大腸菌におけるピルビン酸応答転写因子PdhRが、脂質の異化経路をはじめとするピルビン酸に直接作用する複数の代謝経路や、細胞の運動性に関与する遺伝子群の発現を制御していることを発見しました。
本研究は、日本学術振興会科学研究費補助金及び長瀬科学技術振興財団研究助成金の支援を受けました。研究成果は、英国の国際誌「Microbial Genomics」(電子版)2020年9月25日付に掲載されました。
ピルビン酸は解糖系の最終産物であり、代謝経路の中心に位置しているため、生物の生体内における主要な炭素化合物のひとつです。ピルビン酸の生体内における重要性や、関連する代謝経路を構成する酵素や遺伝子については長い研究の歴史があります。微生物において、細胞内のピルビン酸濃度の変化に適応するために、ピルビン酸応答転写因子PdhR(pyruvate dehydrogenase regulator)による転写制御が知られていました。しかしながらこれまでのPdhRの役割は特定の遺伝子の制御に限られており、ゲノム全体に対する役割までは分かっていませんでした。
本研究グループは大腸菌をモデル生物として、1つの生物の遺伝子制御の全体像の理解を目指しています。その一環で、PdhRについて、Genomic SELEX法を用いてゲノム上の結合領域を決定したところ、脂質の異化経路、TCA回路や乳酸代謝経路、グリコール酸代謝経路などのピルビン酸に関与する代謝経路、また、鞭毛形成を制御する調節因子などの遺伝子群を制御標的としていることが同定されました(図1)。実際に遺伝子発現への影響を検証したところ、PdhRはピルビン酸低濃度時に脂質の異化経路の遺伝子群の発現を活性化していることが分かりました。さらに細胞内の脂質の濃度を測定したところ、PdhRにより脂質量が低下していることが観察されました。これにより、ピルビン酸濃度が低下した際、PdhRの制御を介して脂質を分解することで、炭素化合物を供給していることが示唆されました(図2)。さらに、TCA回路や乳酸代謝経路、グリコール酸代謝経路などの遺伝子群も制御していることが分かりました。また、PdhRは鞭毛形成遺伝子群を抑制化していることが分かり、実際に運動性を抑制化していることが分かりました(図3)。これらのことから、PdhRは細胞内のピルビン酸濃度に応答し、脂質の分解をはじめとした複数の代謝経路を制御することで細胞内のピルビン酸濃度の恒常性を維持していること、また運動性を制御していることが示唆されました(図4)。

図1. 本研究グループにより独自に開発されたGenomic SELEX法を用いて同定されたPdhRのゲノム上結合領域および主要な制御標的遺伝子群。

図2. PdhRが細胞内の脂質濃度に与える影響。脂質の組成(A)と総脂質量(B)の定量結果。
図3. PdhRが運動性に与える影響。軟寒天培地上での大腸菌の運動性試験結果(A)とその比較(B)。

図4. 炭素源代謝におけるPdhRの標的遺伝子群。赤がPdhRにより活性化、青が抑制化される遺伝子を示す。
本研究グループは1つの生物の遺伝子発現制御機構の全体像を理解する目的で、大腸菌をモデル生物としてこれまでに数々の転写因子の機能同定に成功してきました。特に、本研究で新規機能が明らかとなったPdhR以外にも、グルコース飢餓に応答するCRP(cAMP receptor protein)や、細胞内のフルクトース-1Pなどに応答するCra(catabolite repressor activator)といった炭素源代謝の制御に重要なグローバルレギュレーターによる新規な遺伝子発現機構をゲノムスケールで明らかにしてきました。これらの機能解析は、生物の中心代謝経路を制御する仕組みの理解に役立つことはもちろんのこと、微生物を利用した物質生産にとっても役立ちます。これまでは、これらグローバルレギュレーターの本質的な役割を理解しないままに物質生産を目的とした微生物の代謝改変に用いられてきましたが、本研究成果により、目的物質の生産に最適化した本質的な代謝改変が可能となり、微生物の物質生産能力の向上にも役立つことが期待されます。
論文情報
掲載誌 : |
Microbial Genomics |
論文タイトル : |
Expanded roles of pyruvate-sensing PdhR in transcription regulation of the Escherichia coli K-12 genome: fatty acid catabolism and cell motility |
著者 : |
Takumi Anzai, Sousuke Imamura, Akira Ishihama and Tomohiro Shimada |
DOI : |
お問い合わせ先
東京工業大学 科学技術創成研究院 化学生命科学研究所
准教授 今村壮輔
E-mail : simamura@res.titech.ac.jp
明治大学農学部農芸化学科 応用生化学研究室
専任准教授 島田友裕
E-mail : tomoshimada@meiji.ac.jp
Tel : 044-934-7102
取材申し込み先
東京工業大学 総務部 広報課
E-mail : media@jim.titech.ac.jp
Tel : 03-5734-2975 / Fax : 03-5734-3661
明治大学 広報課
E-mail : koho@mics.meiji.ac.jp
Tel : 03-3296-4082